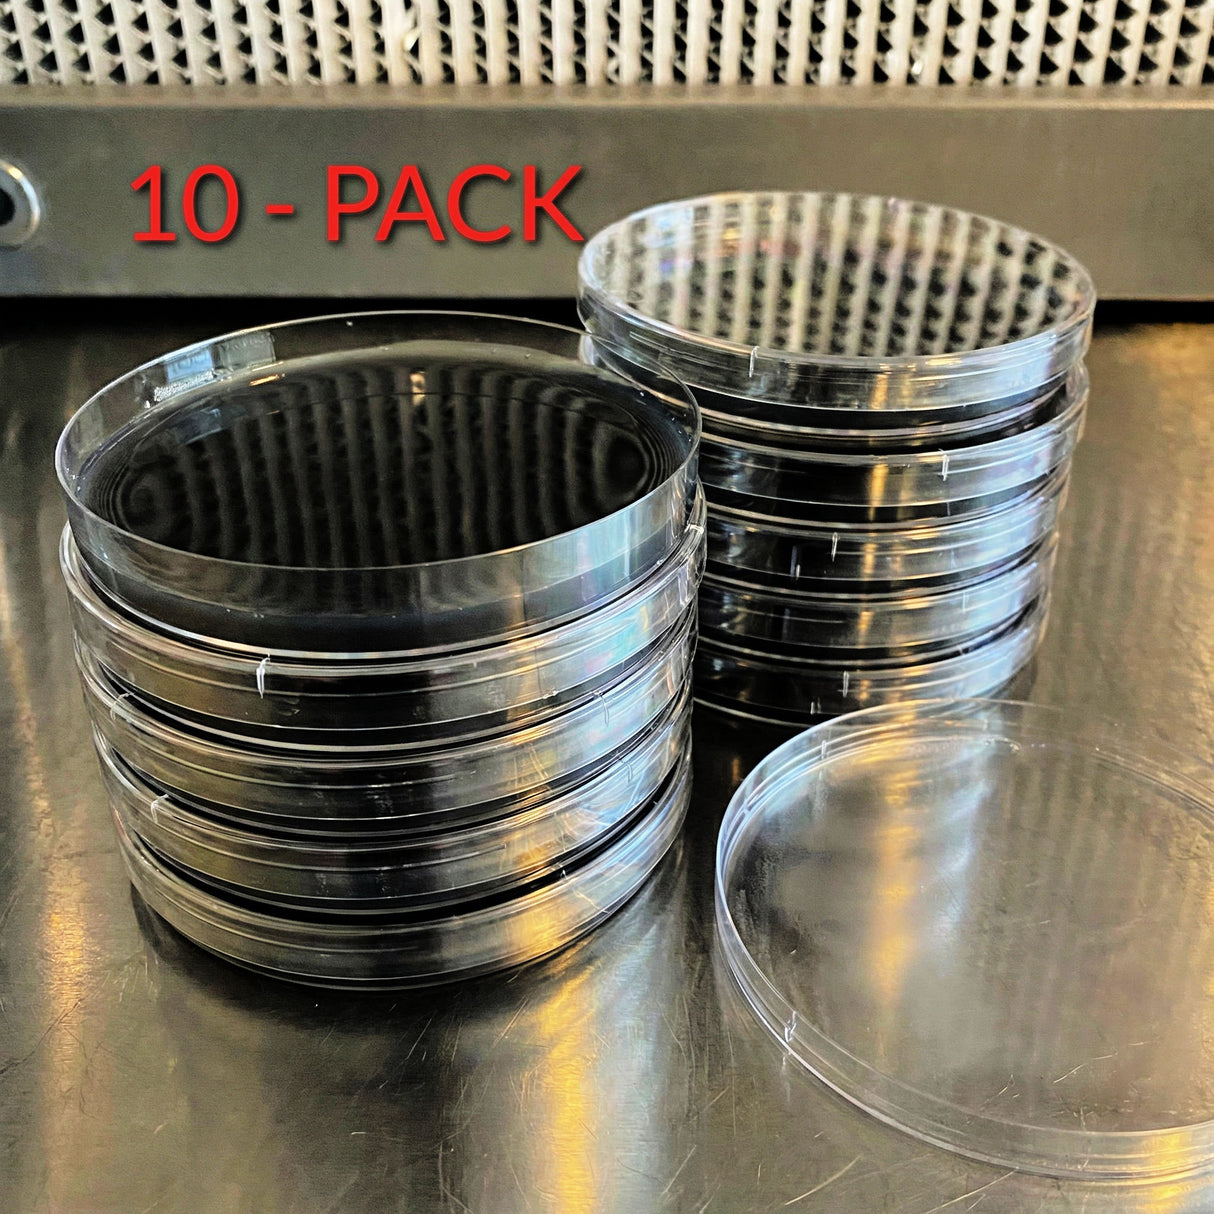
Stack of black carbon agar plates with '10-Pack' text on a metallic surface
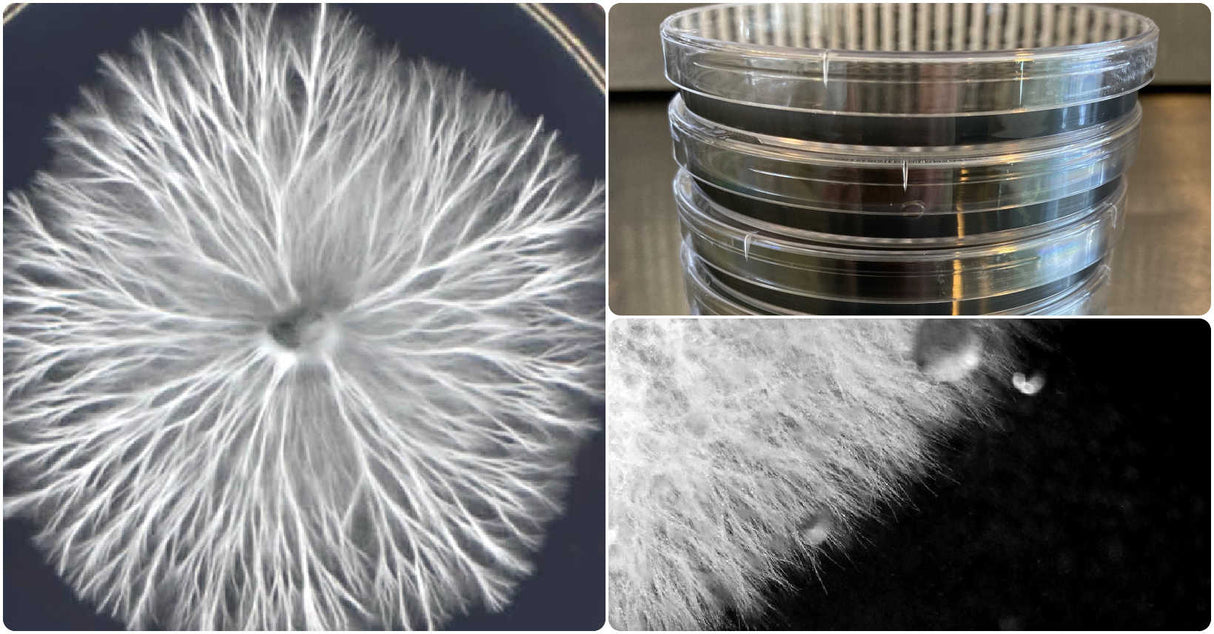
Pre-Poured Sterilized BLACK MEA Agar Plates
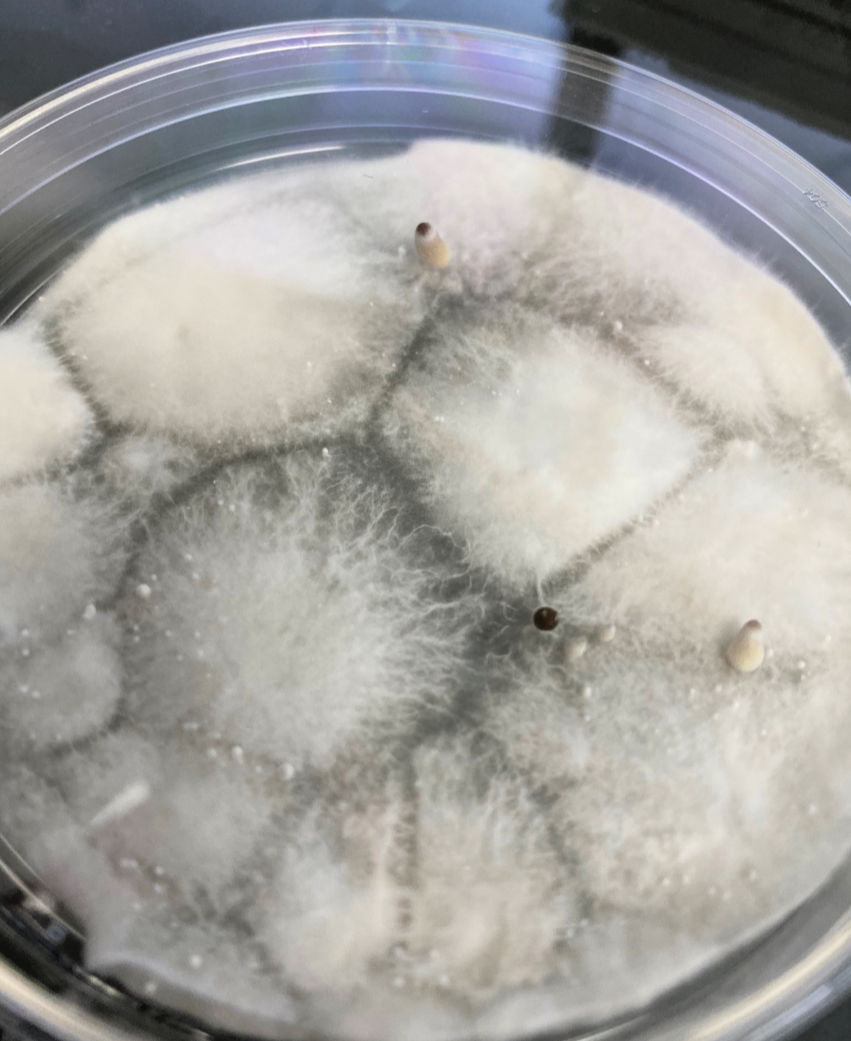
Pre-Poured Sterilized BLACK MEA Agar Plates mushroom pinning

Pre-Poured Sterilized BLACK MEA Agar Plates (10-Pack)
Pre-Poured Sterilized BLACK MEA Agar Plates (10-Pack) is backordered and will ship as soon as it is back in stock.
Couldn't load pickup availability
Description
Description
Pre-Poured Sterilized BLACK MEA Agar Plates (10-Pack)
Freshly Poured Daily · Carbon-Rich · Maximum Contrast for Mycelium Evaluation
360° view: bright white mycelium against deep black MEA for optimal contrast and sector visibility.
Take your culture work to the next level with Myco Labs Black MEA Agar Plates. Specially formulated with activated carbon, these 100mm plates provide exceptional visual contrast—making white or light-colored mycelium stand out clearly against a deep black background.
Poured fresh daily in a clean-room workflow and sealed for protection, Black MEA plates make it easier to observe morphology, detect early contamination, and isolate your strongest genetics with confidence.
What’s Included
- (10) Sterilized BLACK MEA Agar Plates
- 100mm Polystyrene Petri Dishes – durable, lab-grade clarity
- Carbon-infused MEA formula for enhanced visibility
Why Choose Black Agar Plates?
- Maximum Contrast – white mycelium pops against the dark surface
- Improved Sector Identification – easier to see growth edges and isolate clean transfers
- Carbon-Enriched Formula – activated carbon may help reduce bacterial spread
- Chloramphenicol Infused – helps suppress common bacterial contamination*
- Machine Poured & Pressure Sterilized for consistency and reliability
- Storage: refrigerate and use within 3–4 weeks for peak performance
*Antibiotics assist with certain bacteria but do not replace sterile technique.
What Is Black Agar & Why Use It?
Black agar is a nutrient-rich malt extract medium infused with activated carbon, giving it its dark appearance. It serves three primary purposes in mushroom culture work:
- Contrast: Makes white/light mycelium highly visible.
- Clarity: Helps identify morphology, sectoring, and pigmentation.
- Cleaner Evaluation: Easier detection of subtle contamination or mixed growth.
Simply place a small drop of spore solution, tissue, or liquid culture onto the plate and incubate. Once growth appears, transfer a clean wedge to grain jars, spawn bags, or liquid culture for expansion.
Which Agar Plate Should I Choose?
Each agar type serves a specific purpose in your workflow. Here’s a quick comparison to help you choose:
| Agar Type | Best For | Why Growers Use It | Recommended Stage |
|---|---|---|---|
| Black MEA (This Listing) | High contrast evaluation, isolation, showcase plates | Dark background makes sectors and edges easier to see | Any stage (ideal for detailed evaluation) |
| Regular LME / MEA | Spore germination, first plates, contamination checks | Reliable baseline media for early-stage culture work | Start here → first transfer |
| Rapid Rhizo | 2nd & 3rd transfers, aggressive sector isolation | Encourages strong rhizomorphic, threadlike growth | After clean-up → final transfers |
| Manure-Enriched / Conditioning Agar | Performance testing, conditioning for bulk substrates | Tests genetics on richer, supplemented nutrition | Mid-to-late stage |
Black MEA (This Listing)
Regular LME / MEA
Rapid Rhizo
Manure-Enriched / Conditioning Agar
Lab Precision in Every Plate
All of our agar plates are machine-poured for unmatched consistency and sterility:
- Mixed and sterilized at 18 PSI for 30 minutes
- Poured at ~145°F with precise 25ml per plate
- UV-C sanitized, capped, and laser-labeled
Our automated MediaFill workflow ensures uniform volume, cleanliness, and quality—every single time.
See How Our Black Agar Plates Are Made
Watch our clean-room workflow and automated agar pouring system in action—from sterilization to precision filling. This is the same controlled process used for every Black MEA plate we produce.
Behind the scenes: MediaPrep sterilization, precision fills, UV-C sanitization, and clean-room workflow.